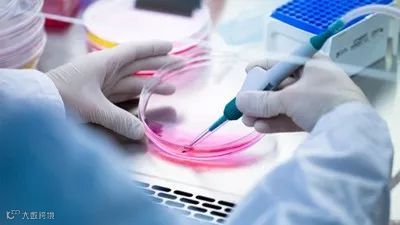

脐带血是胎儿娩出时残留在脐带和胎盘中的血液,含有可以重建人体造血和免疫系统的造血干细胞,在血液系统疾病、免疫系统疾病等80多种恶性疾病的治疗方面显示出了巨大潜力,是非常宝贵的生命资源。
作为造血干细胞重要来源之一,近年来脐带血的价值得到越来越多人的认可,“世界脐带血日”随之应运而生。2017年11月15日,由“Save the Cord Foundation”组织和主办的首个“世界脐带血日”在美国诞生,以“脐带血教育是关键”为宗旨,大力宣传科普脐带血相关知识。
曾经很长一段时间里,脐带血是作为废弃的血液处理掉的,而今,随着脐带血研究与应用的不断深入,它已经成为临床造血干细胞的重要来源之一。
1988年,法国医生格鲁克曼完成了世界上首例脐带血造血干细胞移植手术,治愈了年仅5岁罹患严重范可尼贫血的马克.法罗。如今的他不仅已健康生活30多年,并且和正常人一样娶妻生子,过上了幸福的生活。可以说,格鲁克曼医生的一小步,迈出了脐带血应用史上的一大步。
随后,脐带血应用发展势如破竹,创造了越来越多的“首例”:1990年,美国完成首例治疗白血病的脐带血移植;1991年,我国的沈伯钧教授带领科研团队,完成了世界第一例混合脐带血移植,救治了一位4岁的脂肪肉瘤患者;1997年,世界首例自体脐血移植成功,一名14个月的巴西女童,用自体脐带血成功治愈了神经母细胞瘤;2009 年,首都医科大学附属北京儿童医院为一名患有神经母细胞瘤的患儿移植了一份自存的脐带血并获得成功,这也是我国首例自体脐带血移植成功的案例……
经过30余年的医学实践证明,脐带血中含有可以重建人体造血和免疫系统的造血干细胞,是治疗很多难治性疾病的“有力武器”。中国科技大学附属第一医院主任医师、教授、博士生导师孙自敏曾在受访时表示,正是由于脐带血的本质特性,脐带血移植后GVHD(移植物抗宿主病)的发生率低,复发率低,在一定程度上缓解了恶性疾病治疗过程中的巨大难题,为患者提供了完全治愈的可能。也因此,脐带血在血液系统、免疫系统和部分恶性肿瘤等重大疾病的治疗方面发挥着极其重要的作用。据美国纽约血液中心(NYBC)的统计数据表明,脐带血可用于80多种疾病的治疗。
在我国,由国家卫生健康委员会发布的《造血干细胞移植技术管理规范》中也明确规定,包含脐带血在内的造血干细胞移植可适用于急慢性白血病、骨髓增生异常综合征、淋巴瘤、多发性骨髓瘤、其他某些恶性肿瘤、再生障碍性贫血、重症放射病等疾病的临床研究。

孙媛是我国著名儿童血液移植技术专家,是北京京都儿童医院血液肿瘤中心主任。孙媛教授早在2009 年就为我国一名儿童重型再生障碍性贫血患者进行XIAP 相关噬血细胞综合征造血干细胞移植和首例自体脐带血移植。在北京京都儿童医院,孙教授和她的团队有大量成功为重型再生障碍性贫血和实体瘤进行脐带血移植的案例。在2019 年8 月举行的脐带血大会上,孙媛教授曾列举了11 名使用自体脐带血回输治疗再障的案例。近期回访这11 名患者发现,移植后存活率达到了100%。通过多年的临床实践和科学探索,孙媛以及她的团队认识到了脐带血的医学价值,她表示脐带血是孩子生命的备份,储存脐带血很有意义。
宝宝自体储存的脐带血有四分之一的机率与兄弟姐妹配型全相合,而宝宝的父母与其配型至少半相合,因此储存脐带血不但是为孩子做一个生命备份,而且是为家庭留下一份健康保障。北京大学航天中心医院血液科主任王静波教授强调,自体储存脐带血其实并不是仅仅为了一个孩子,同时也是为了家里人,不仅可以给父母使用,还可以救助其他家族成员。因为我国独生子女政策的推行,目前许多三四十岁的病人一旦生病,面临没有供体的难题。此时,如果在孩子出生时存了脐带血,亲缘的半相合脐带血移植就非常有意义了。

近年来,随着科学技术的不断进步,越来越多的科学家开始使用脐带血治疗更多的难治性疾病,脐带血在更多疑难病的临床应用也在持续开展,临床应用范围正在不断拓展,并取得了很多突破。
截至2018年底,国际上注册与脐带血相关的科学研究项目近400项,涉及自身免疫性疾病、心脑血管疾病、整形外科等相关疾病。
2017年10月,美国FDA批准了由美国杜克大学的Joanne Kurtzberg教授主持的脐带血治疗儿童脑损伤的扩大范围临床试验,涉及疾病包括缺少治疗手段、却有着更高发病率的自闭症、脑瘫、脑积水、语言障碍等。另据报道,脐带血在治疗艾滋病、帕金森症、脑卒中等疾病上都有新的尝试与突破。
据美国脐带血公益网站ParentsGuide上的数据显示,日本、美国等发达国家的脐带血应用范围更加广泛,除了造血干细胞移植治疗外,在再生医学领域尤其是神经系统疾病方面的应用比例正在快速增长,越来越多的家庭从中获益。

如果对您有帮助,请转发到朋友圈让您的朋友因此而受益!








 中源协和辽宁细胞资源库
中源协和辽宁细胞资源库